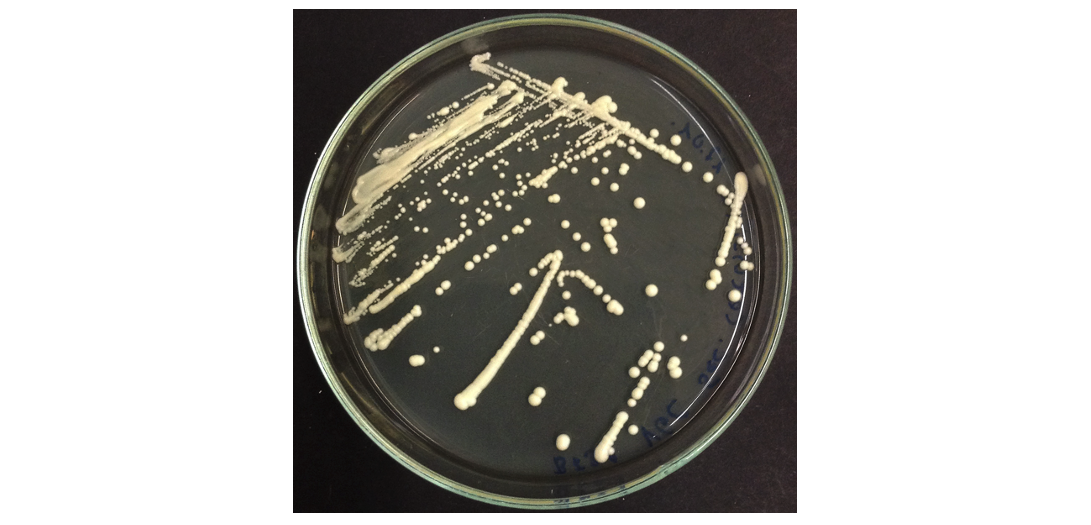

Lo Studio di modelli alternativi alla sperimentazione animale per valutare varie patologie è al centro dell’impegno della comunità scientifica internazionale.
Negli ultimi mesi, forte di questa necessità di sostituire la sperimentale animale con modelli biologici nuovi, ho sviluppato tecniche di sviluppo di tumori e di valutazione di tossicità di sostanze naturali su modelli di Saccharomyces e Uova non fecondato di pollo con notevoli risultati.
Risultati che hanno portato al chiarimento di importanti valutazioni scientifiche su sostanze naturali condotte da terzi in maniera non corretta o con l’utilizzo di modelli biologici errati come nel caso della presunta genotossicità dell’aloe e dei derivati idrossiantracenici che grazie a mie relazioni basate su questi modello innovativi sono riuscite a smentire i dati e le conclusioni errate proposte da L’ EFSA.
Dobbiamo continuare su questa strada per sviluppare sempre più nuove metodiche.
Expert Herbal Chemist and Consultant
Phytochemical Quality Control, Research and Pharmacognostic Evaluation of Medicinal Plant Extracts
Rome – Italy
Tel:351/0461450
E-mail: paolo.pelini@gmail.com
http://www.paolopelinierbochimico.it